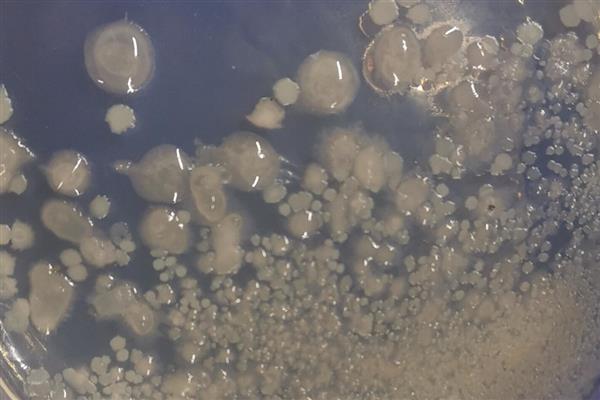

消毒:将缸内的水全部排出,各种设备也全部取出,再重新灌满水到缸内,加入消毒剂浸泡3-4小时,清洗完后进行晾晒。
养水加培菌:将自来水在太阳底下晾晒1-2天后装入缸内,并往水中加入硝化细菌。
闯缸鱼试水:水养好后,先放闯缸鱼试试水,一般用草金做闯缸鱼较好,若能将其养活一两周时间,就可以将其他鱼儿放入缸中了。

一、鱼死亡后如何重新开缸
1、开缸先消毒
(1)既然是重新开缸,第一步就是要消毒了,将缸内的水排空,并将过滤等设备拿出来,鱼缸里不要再装东西。
(2)缸空了之后,往里面灌满水,然后倒入高锰酸钾等消毒剂,浸泡鱼缸3-4个小时。之后就可以水排空,然后用清水洗去残留的药物,并放到太阳底下晒一晒。

2、养水加培菌
(1)开缸的第二步是养水,水养好了才能养好鱼。开缸的水一定要用晾晒过的自来水,如果是白天晒的话,晒1-2天就可以了,如果不是放到太阳底下晒,则要晾一周的时间才可以用。
(2)将困过的水倒入鱼缸中,并往里面加入硝化细菌,这样可以建立硝化系统,从而避免水中氨氮过量,对鱼儿造成毒害。
3、闯缸鱼试水
(1)养水过程中,一般水会先变得浑浊,之后恢复清澈,这就说明水养好了,不过为了保险起见,最好先放闯缸鱼试试水。
(2)通常选用草金作为闯缸鱼,本身皮实好养,而且对温度的要求不高,能养活一两周的时间,就可以将想要养的鱼投放了。
(3)如果闯缸鱼陆续死亡,则说明缸没开好或水有问题,可以先找找原因,再想方法。

二、新买的鱼缸如何开缸
1、消毒
(1)新买的鱼缸首先要做的就是消毒,虽然说新鱼缸没养过鱼,不会有什么有害菌,但消过毒后更保险一些。
(2)先要往缸中注满水,然后倒入适量的高锰酸钾,浸泡3-4个小时左右。泡完后将水排掉,再冲洗几次以免药物残留。

2、养水
(1)养鱼一定要先养好水。如果有足够多的容器,可以先接好水放到太阳底下晒一晒,然后再把晒过的水注入鱼缸。
(2)如果鱼缸太大,晒水不够用的话,可以直接将水注入鱼缸,静置一周的时间,也能除氯。另外,有过滤和充氧设备的话,可以缩短养水的时间。

3、培菌
(1)鱼缸里不仅有鱼,还需要其它的有益菌,其中最重要的就是硝化细菌。因为鱼的排泄物会被分解,分解会产生氨氮,这会对鱼儿造成毒害,通过培养硝化细菌,建立硝化系统,可以将氨氮转化为无害的硝酸盐。
(2)培菌的方法也很简单,只要将培菌的原料倒入,然后关灯爆氧即可。

4、放鱼
培菌过程中,鱼缸内的水会先变得浑浊,然后恢复清澈,这个时候的水就基本养好了,但最好先用闯缸鱼试试水,如果养了一到两周没问题,就可以正式放鱼了。


